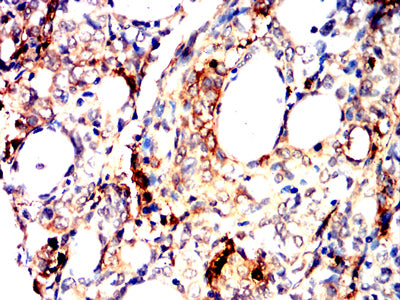

Mouse Monoclonal Antibody to TPSAB1
货号:
32399
别名:
TPS1; TPS2; TPSB1; TPSB2; Tryptase-2
应用:
IHC,FCM
反应种属:
Human, Rat
抗体类型:
Primary antibody
Swissprot:
Q15661
规格:
目录价
在线咨询
Description |
|---|
Tryptases comprise a family of trypsin-like serine proteases, the peptidase family S1. Tryptases are enzymatically active only as heparin-stabilized tetramers, and they are resistant to all known endogenous proteinase inhibitors. Several tryptase genes are clustered on chromosome 16p13.3. These genes are characterized by several distinct features. They have a highly conserved 3' UTR and contain tandem repeat sequences at the 5' flank and 3' UTR which are thought to play a role in regulation of the mRNA stability. These genes have an intron immediately upstream of the initiator Met codon, which separates the site of transcription initiation from protein coding sequence. This feature is characteristic of tryptases but is unusual in other genes. The alleles of this gene exhibit an unusual amount of sequence variation, such that the alleles were once thought to represent two separate genes, alpha and beta 1. Beta tryptases appear to be the main isoenzymes expressed in mast cells; whereas in basophils, alpha tryptases predominate. Tryptases have been implicated as mediators in the pathogenesis of asthma and other allergic and inflammatory disorders. |
References |
|---|
| 1.Biomaterials. 2019 Mar;197:72-85. 2.J Allergy Clin Immunol. 2021 Feb;147(2):622-632. |
Specification |
|
|---|---|
| Aliases | TPS1; TPS2; TPSB1; TPSB2; Tryptase-2 |
| Entrez GeneID | 7177 |
| Swissprot | Q15661 |
| clone | 6B6B12 |
| WB Predicted band size | 30.5kDa |
| Host/Isotype | Mouse IgG2b |
| Antibody Type | Primary antibody |
| Storage | Store at 4°C short term. Aliquot and store at -20°C long term. Avoid freeze/thaw cycles. |
| Species Reactivity | Human, Rat |
| Immunogen | Purified recombinant fragment of human TPSAB1 (AA: 31-275) expressed in E. Coli. |
| Formulation | Purified antibody in PBS with 0.05% sodium azide |
Application |
|
|---|---|
| IHC | 1/200 - 1/1000 |
| FCM | 1/200 - 1/400 |
| ELISA | 1/10000 |
Product Image
-
Black line: Control Antigen (100 ng);Purple line: Antigen (10ng); Blue line: Antigen (50 ng); Red line:Antigen (100 ng)

-
Flow cytometric analysis of HepG2 cells using TPSAB1 mouse mAb (green) and negative control (red).

-
Immunohistochemical analysis of paraffin-embedded rat kidney tissues using TPSAB1 mouse mAb with DAB staining.

-
Immunohistochemical analysis of paraffin-embedded human lung cancer tissues using TPSAB1 mouse mAb with DAB staining.

-
Immunohistochemical analysis of paraffin-embedded human cervical cancer tissues using TPSAB1 mouse mAb with DAB staining.

-
Immunohistochemical analysis of paraffin-embedded rabbit kidney tissues using TPSAB1 mouse mAb with DAB staining.

鄂公网安备42018502007531号

